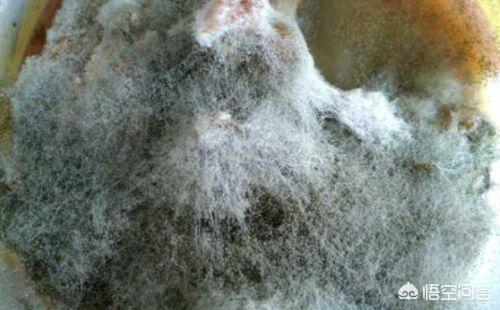
菌的拼音 菌的拼音怎么写

菌拼音:jūn,jùn 基本信息:部首:艹,四角码:44600,仓颉:twhd 86五笔:altu,98五笔:altu,郑码:EJMF 统一码:83CC,总笔画数:11 基本解释:
例如在下列词语中读jūn: 真菌 酵母菌 青霉菌 但是,表示“真菌”中的“伞菌科各种真菌”(种类很多,有的能食用,例如香菇)的意思时,读四声。
例如在以下词语中读jùn: 香菌 菌子 菌种(杜永道)问题二:菌的拼音是。

食用菌的菌怎么读菌在这里读作:jùn 菌拼音:jūn、 jùn 释义:1、jūn:低等植物的一大类,不开花,没有茎和叶子,不含叶绿素,不能自己制造养料,过寄生生活,种类繁多:细菌。
真菌。
病菌。
菌肥。
2、jùn:即“蕈”。
〔蕈树〕常绿。
1、菌拼音:[jūn]、[jùn]。
2、基本释义 :(1)[ jūn ]:某些低等生物,以寄生或腐生方式摄取营养,如细菌、黏菌、真菌等。
(2)[ jùn ]:蕈(xùn)。
3、相关组词:杀菌、细菌、霉菌、真菌、杆菌、黏菌、球菌、。
菌拼音:[jūn,jùn][释义] [jūn]:低等植物的一大类,不开花,没有茎和叶子,不含叶绿素,不能自己制造养料,过寄生生活,种类繁多。
[jùn]:即“蕈”。